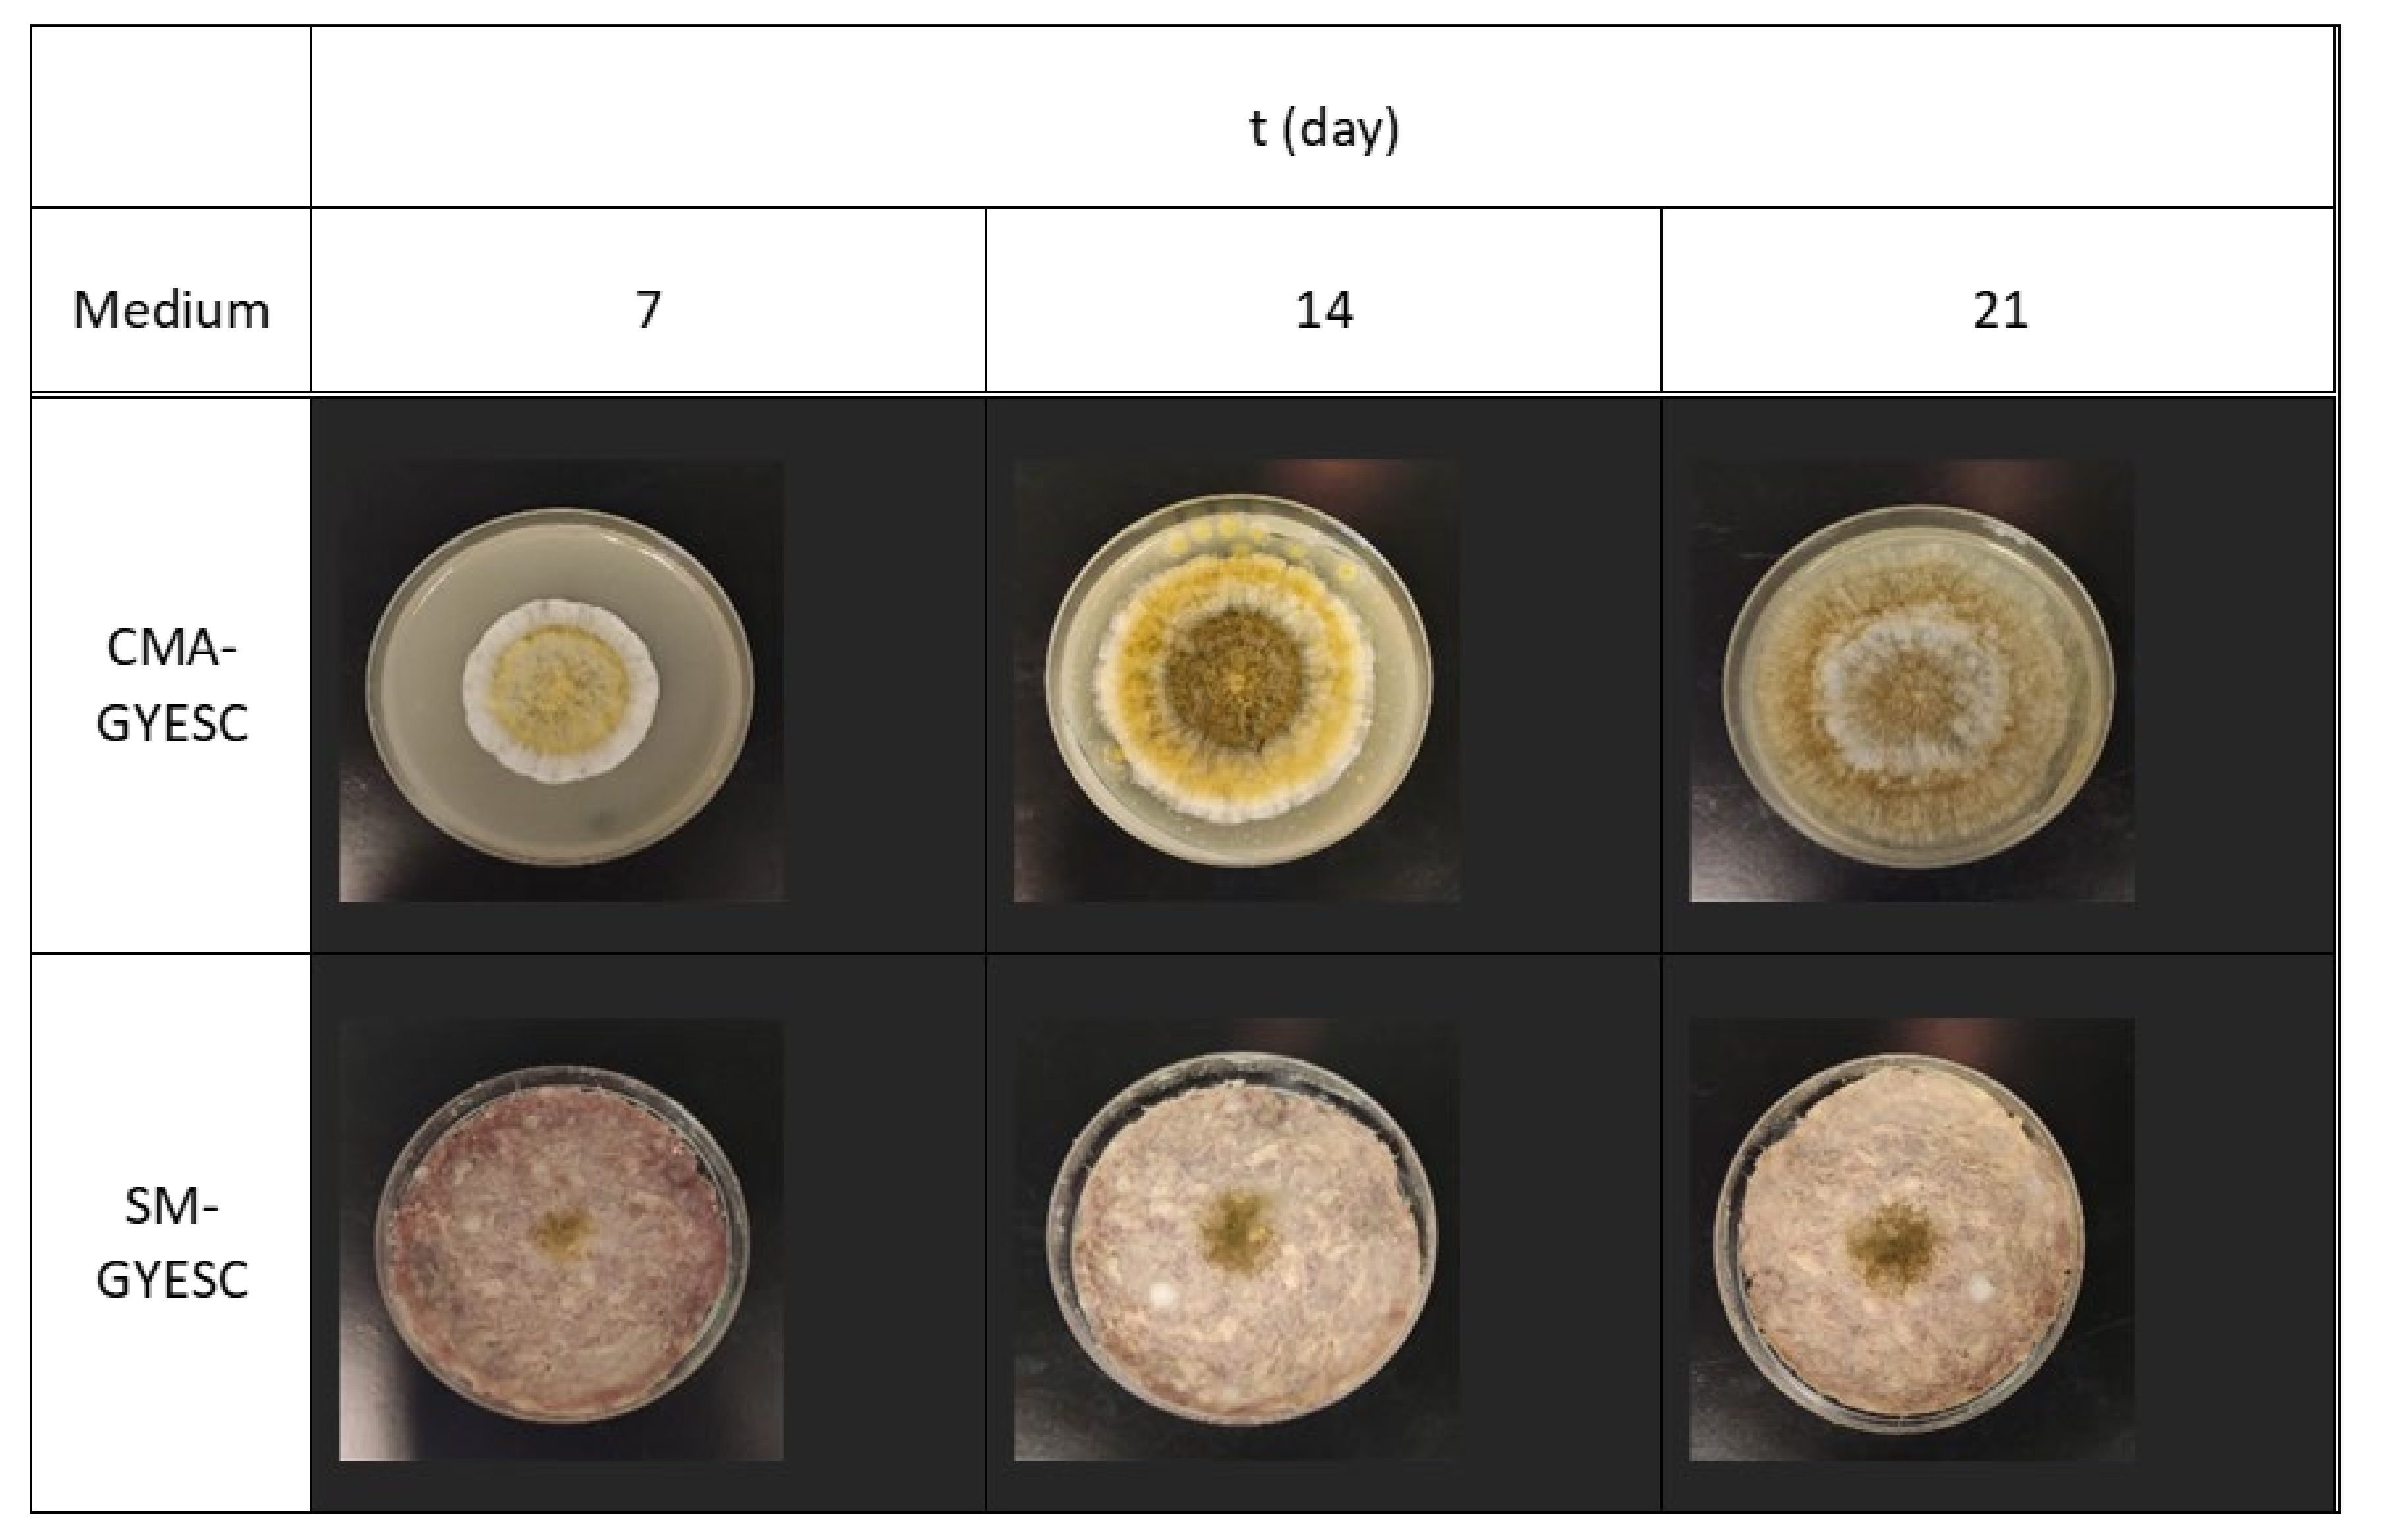
Toxins 16 00173 g004

Meat Starter Culture Reduces Aspergillus parasiticus Production of Aflatoxins on Meat-Based and Salami Model Media
Abstract
1. Introduction
2. Results and Discussion
2.1. Effect of Meat Starter Culture on A. parasiticus Growth and Mycotoxin Production on Meat-Based Media
2.2. Effect of Meat Starter Culture on A. parasiticus Growth and Mycotoxin Production on Salami Model Medium
2.3. Relation between A. parasiticus Growth and AFB1 Production on Meat-Based and Salami Model Media
3. Conclusions
4. Materials and Methods
4.1. Microorganisms and Culture Conditions
4.2. Culture Media Preparation
4.3. Experimental Conditions and Design of Experimental Work
4.4. Assessment of A. parasiticus Growth
4.5. Extraction and Quantification of Aflatoxins and Sterigmatocystin
4.5.1. Sampling and Mycotoxin Extraction
4.5.2. Quantification of AF and STE by UPLC–MS/MS Analysis
4.6. Statistical Analysis
Supplementary Materials
Author Contributions
Funding
Institutional Review Board Statement
Informed Consent Statement
Data Availability Statement
Conflicts of Interest
References
- Rodríguez, A.; Rodríguez, M.; Martín, A.; Delgado, J.; Córdoba, J.J. Presence of Ochratoxin A on the Surface of Dry-Cured Iberian Ham after Initial Fungal Growth in the Drying Stage. Meat Sci. 2012, 92, 728–734. [Google Scholar] [CrossRef] [PubMed]
- Alapont, C.; López-Mendoza, M.C.; Gil, J.V.; Martínez-Culebras, P.V. Mycobiota and Toxigenic Penicillium Species on Two Spanish Dry-Cured Ham Manufacturing Plants. Food Addit. Contam. Part A 2014, 31, 93–104. [Google Scholar] [CrossRef] [PubMed]
- Pleadin, J.; Lešić, T.; Milićević, D.; Markov, K.; Šarkanj, B.; Vahčić, N.; Kmetič, I.; Zadravec, M. Pathways of Mycotoxin Occurrence in Meat Products: A Review. Processes 2021, 9, 2122. [Google Scholar] [CrossRef]
- Tolosa, J.; Rodríguez-Carrasco, Y.; Ruiz, M.J.; Vila-Donat, P. Multi-Mycotoxin Occurrence in Feed, Metabolism and Carry-over to Animal-Derived Food Products: A Review. Food Chem. Toxicol. 2021, 158, 112661. [Google Scholar] [CrossRef] [PubMed]
- Núñez, F.; Rodríguez, M.M.; Bermúdez, M.E.; Córdoba, J.J.; Asensio, M.A. Composition and Toxigenic Potential of the Mould Population on Dry-Cured Iberian Ham. Int. J. Food Microbiol. 1996, 32, 185–197. [Google Scholar] [CrossRef] [PubMed]
- Lešić, T.; Zadravec, M.; Zdolec, N.; Vulić, A.; Perković, I.; Škrivanko, M.; Kudumija, N.; Jakopović, Ž.; Pleadin, J. Mycobiota and Mycotoxin Contamination of Traditional and Industrial Dry-Fermented Sausage Kulen. Toxins 2021, 13, 798. [Google Scholar] [CrossRef] [PubMed]
- Perrone, G.; Rodriguez, A.; Magista, D.; Magan, N. Insights into Existing and Future Fungal and Mycotoxin Contamination of Cured Meats. Curr. Opin. Food Sci. 2019, 29, 20–27. [Google Scholar] [CrossRef]
- Kudumija, N.; Vulić, A.; Lešić, T.; Vahčić, N.; Pleadin, J. Aflatoxins and Ochratoxin A in Dry-Fermented Sausages in Croatia, by LC-MS/MS. Food Addit. Contam. Part B 2020, 13, 225–232. [Google Scholar] [CrossRef] [PubMed]
- IARC Working Group on the Evaluation of Carcinogenic Risks to Humans; International Agency for Research on Cancer; World Health Organization. Some Traditional Herbal Medicines, Some Mycotoxins, Naphthalene and Styrene; World Health Organization: Geneva, Switzerland, 2002; ISBN 978-92-832-1282-9. [Google Scholar]
- Bennett, J.W.; Klich, M. Mycotoxins. Clin. Microbiol. Rev. 2003, 16, 497–516. [Google Scholar] [CrossRef] [PubMed]
- Hedayati, M.T.; Pasqualotto, A.C.; Warn, P.A.; Bowyer, P.; Denning, D.W. Aspergillus flavus: Human Pathogen, Allergen and Mycotoxin Producer. Microbiology 2007, 153, 1677–1692. [Google Scholar] [CrossRef] [PubMed]
- Mahato, D.K.; Lee, K.E.; Kamle, M.; Devi, S.; Dewangan, K.N.; Kumar, P.; Kang, S.G. Aflatoxins in Food and Feed: An Overview on Prevalence, Detection and Control Strategies. Front. Microbiol. 2019, 10, 483502. [Google Scholar] [CrossRef] [PubMed]
- Ehrlich, K.C.; Kobbeman, K.; Montalbano, B.G.; Cotty, P.J. Aflatoxin-Producing Aspergillus Species from Thailand. Int. J. Food Microbiol. 2007, 114, 153–159. [Google Scholar] [CrossRef] [PubMed]
- Díaz Nieto, C.H.; Granero, A.M.; Zon, M.A.; Fernández, H. Sterigmatocystin: A Mycotoxin to Be Seriously Considered. Food Chem. Toxicol. 2018, 118, 460–470. [Google Scholar] [CrossRef] [PubMed]
- Zingales, V.; Fernández-Franzón, M.; Ruiz, M.-J. Sterigmatocystin: Occurrence, Toxicity and Molecular Mechanisms of Action —A Review. Food Chem. Toxicol. 2020, 146, 111802. [Google Scholar] [CrossRef] [PubMed]
- EFSA Scientific Opinion on the Risk for Public and Animal Health Related to the Presence of Sterigmatocystin in Food and Feed|EFSA. Available online: https://www.efsa.europa.eu/en/efsajournal/pub/3254 (accessed on 31 August 2023).
- Lešić, T.; Vulić, A.; Vahčić, N.; Šarkanj, B.; Hengl, B.; Kos, I.; Polak, T.; Kudumija, N.; Pleadin, J. The Occurrence of Five Unregulated Mycotoxins Most Important for Traditional Dry-Cured Meat Products. Toxins 2022, 14, 476. [Google Scholar] [CrossRef] [PubMed]
- Hugas, M.; Monfort, J.M. Bacterial Starter Cultures for Meat Fermentation. Food Chem. 1997, 59, 547–554. [Google Scholar] [CrossRef]
- Laranjo, M.; Elias, M.; Fraqueza, M.J. The Use of Starter Cultures in Traditional Meat Products. J. Food Qual. 2017, 2017, e9546026. [Google Scholar] [CrossRef]
- Laranjo, M.; Potes, M.E.; Elias, M. Role of Starter Cultures on the Safety of Fermented Meat Products. Front. Microbiol. 2019, 10, 441960. [Google Scholar] [CrossRef]
- Møller, C.O.d.A.; Freire, L.; Rosim, R.E.; Margalho, L.P.; Balthazar, C.F.; Franco, L.T.; Sant’Ana, A.d.S.; Corassin, C.H.; Rattray, F.P.; de Oliveira, C.A.F. Effect of Lactic Acid Bacteria Strains on the Growth and Aflatoxin Production Potential of Aspergillus Parasiticus, and Their Ability to Bind Aflatoxin B1, Ochratoxin A, and Zearalenone in Vitro. Front. Microbiol. 2021, 12, 655386. [Google Scholar] [CrossRef]
- Rämö, S.; Kahala, M.; Joutsjoki, V. Aflatoxin B1 Binding by Lactic Acid Bacteria in Protein-Rich Plant Material Fermentation. Appl. Sci. 2022, 12, 12769. [Google Scholar] [CrossRef]
- Simões, L.; Fernandes, N.; Teixeira, J.; Abrunhosa, L.; Dias, D.R. Brazilian Table Olives: A Source of Lactic Acid Bacteria with Antimycotoxigenic and Antifungal Activity. Toxins 2023, 15, 71. [Google Scholar] [CrossRef] [PubMed]
- Bhat, R.; Rai, R.V.; Karim, A.A. Mycotoxins in Food and Feed: Present Status and Future Concerns. Compr. Rev. Food Sci. Food Saf. 2010, 9, 57–81. [Google Scholar] [CrossRef]
- Chen, Y.; Chen, J.; Zhu, Q.; Wan, J. Ochratoxin A in Dry-Cured Ham: OTA-Producing Fungi, Prevalence, Detection Methods, and Biocontrol Strategies—A Review. Toxins 2022, 14, 693. [Google Scholar] [CrossRef] [PubMed]
- Asensio, M.A.; Núñez, F.; Delgado, J.; Bermúdez, E. Control of Toxigenic Molds in Food Processing. In Microbial Food Safety and Preservation Techniques; Rai, V.R., Bai, J.A., Eds.; CRC Press: Boca Raton, FL, USA, 2014; pp. 329–358. ISBN 978-1-4665-9307-7. [Google Scholar]
- Peromingo, B.; Andrade, M.J.; Delgado, J.; Sánchez-Montero, L.; Núñez, F. Biocontrol of Aflatoxigenic Aspergillus parasiticus by Native Debaryomyces hansenii in Dry-Cured Meat Products. Food Microbiol. 2019, 82, 269–276. [Google Scholar] [CrossRef]
- Crowley, S.; Mahony, J.; van Sinderen, D. Current Perspectives on Antifungal Lactic Acid Bacteria as Natural Bio-Preservatives. Trends Sci. Technol. 2013, 33, 93–109. [Google Scholar] [CrossRef]
- Bangar, S.P.; Sharma, N.; Kumar, M.; Ozogul, F.; Purewal, S.S.; Trif, M. Recent Developments in Applications of Lactic Acid Bacteria against Mycotoxin Production and Fungal Contamination. Food Biosci. 2021, 44, 101444. [Google Scholar] [CrossRef]
- Mateo, E.M.; Tarazona, A.; Jiménez, M.; Mateo, F. Lactic Acid Bacteria as Potential Agents for Biocontrol of Aflatoxigenic and Ochratoxigenic Fungi. Toxins 2022, 14, 807. [Google Scholar] [CrossRef] [PubMed]
- Ben Taheur, F.; Mansour, C.; Kouidhi, B.; Chaieb, K. Use of Lactic Acid Bacteria for the Inhibition of Aspergillus flavus and Aspergillus carbonarius Growth and Mycotoxin Production. Toxicon 2019, 166, 15–23. [Google Scholar] [CrossRef] [PubMed]
- Delgado, J.; da Cruz Cabral, L.; Rodríguez, M.; Rodríguez, A. Influence of Ochratoxin A on Adaptation of Penicillium nordicum on a NaCl-Rich Dry-Cured Ham-Based Medium. Int. J. Food Microbiol. 2018, 272, 22–28. [Google Scholar] [CrossRef] [PubMed]
- Meftah, S.; Abid, S.; Dias, T.; Rodrigues, P. Effect of Dry-Sausage Starter Culture and Endogenous Yeasts on Aspergillus westerdijkiae and Penicillium nordicum Growth and OTA Production. LWT 2018, 87, 250–258. [Google Scholar] [CrossRef]
- Iacumin, L.; Arnoldi, M.; Comi, G. Effect of a Debaryomyces hansenii and Lactobacillus buchneri Starter Culture on Aspergillus westerdijkiae Ochratoxin A Production and Growth during the Manufacture of Short Seasoned Dry-Cured Ham. Microorganisms 2020, 8, 1623. [Google Scholar] [CrossRef]
- Schmidt-Heydt, M.; Abdel-Hadi, A.; Magan, N.; Geisen, R. Complex Regulation of the Aflatoxin Biosynthesis Gene Cluster of Aspergillus flavus in Relation to Various Combinations of Water Activity and Temperature. Int. J. Food Microbiol. 2009, 135, 231–237. [Google Scholar] [CrossRef] [PubMed]
- Gallo, A.; Solfrizzo, M.; Epifani, F.; Panzarini, G.; Perrone, G. Effect of Temperature and Water Activity on Gene Expression and Aflatoxin Biosynthesis in Aspergillus flavus on Almond Medium. Int. J. Food Microbiol. 2016, 217, 162–169. [Google Scholar] [CrossRef] [PubMed]
- Di Gioia, D.; Mazzola, G.; Nikodinoska, I.; Aloisio, I.; Langerholc, T.; Rossi, M.; Raimondi, S.; Melero, B.; Rovira, J. Lactic Acid Bacteria as Protective Cultures in Fermented Pork Meat to Prevent Clostridium Spp. Growth. Int. J. Food Microbiol. 2016, 235, 53–59. [Google Scholar] [CrossRef] [PubMed]
- Zahija, I.; Jeršek, B.; Demšar, L.; Polak, M.L.; Polak, T. Production of Aflatoxin B1 by Aspergillus parasiticus Grown on a Novel Meat-Based Media. Toxins 2023, 15, 25. [Google Scholar] [CrossRef] [PubMed]
- Peromingo, B.; Rodríguez, A.; Bernáldez, V.; Delgado, J.; Rodríguez, M. Effect of Temperature and Water Activity on Growth and Aflatoxin Production by Aspergillus flavus and Aspergillus parasiticus on Cured Meat Model Systems. Meat Sci. 2016, 122, 76–83. [Google Scholar] [CrossRef] [PubMed]
- Cebrián, E.; Núñez, F.; Gálvez, F.J.; Delgado, J.; Bermúdez, E.; Rodríguez, M. Selection and Evaluation of Staphylococcus xylosus as a Biocontrol Agent against Toxigenic Moulds in a Dry-Cured Ham Model System. Microorganisms 2020, 8, 793. [Google Scholar] [CrossRef] [PubMed]
- Caceres, I.; Al Khoury, A.; El Khoury, R.; Lorber, S.; Oswald, I.P.; El Khoury, A.; Atoui, A.; Puel, O.; Bailly, J.-D. Aflatoxin Biosynthesis and Genetic Regulation: A Review. Toxins 2020, 12, 150. [Google Scholar] [CrossRef] [PubMed]
- Calvo, A.M.; Wilson, R.A.; Bok, J.W.; Keller, N.P. Relationship between Secondary Metabolism and Fungal Development. Microbiol. Mol. Biol. Rev. 2002, 66, 447–459. [Google Scholar] [CrossRef]
- Tao, Z.; Yuan, H.; Liu, M.; Liu, Q.; Zhang, S.; Liu, H.; Jiang, Y.; Huang, D.; Wang, T. Yeast Extract: Characteristics, Production, Applications and Future Perspectives. J. Microbiol. Biotechnol. 2023, 33, 151–166. [Google Scholar] [CrossRef] [PubMed]
- Liao, J.; He, Z.; Xia, Y.; Lei, Y.; Liao, B. A Review on Biosynthesis and Genetic Regulation of Aflatoxin Production by Major Aspergillus fungi. Oil Crop Sci. 2020, 5, 166–173. [Google Scholar] [CrossRef]
- Meftah, S.; Abid, S.; Dias, T.; Rodrigues, P. Mechanisms Underlying the Effect of Commercial Starter Cultures and a Native Yeast on Ochratoxin A Production in Meat Products. LWT 2020, 117, 108611. [Google Scholar] [CrossRef]
- Comi, G.; Iacumin, L. Ecology of Moulds during the Pre-Ripening and Ripening of San Daniele Dry Cured Ham. Food Res. Int. 2013, 54, 1113–1119. [Google Scholar] [CrossRef]
- Rodríguez, A.; Capela, D.; Medina, Á.; Córdoba, J.J.; Magan, N. Relationship between Ecophysiological Factors, Growth and Ochratoxin A Contamination of Dry-Cured Sausage Based Matrices. Int. J. Food Microbiol. 2015, 194, 71–77. [Google Scholar] [CrossRef] [PubMed]
- Varnam, A.; Sutherland, J.P. Meat and Meat Products: Technology, Chemistry and Microbiology; Springer Science & Business Media: London, UK, 1995; ISBN 978-0-412-49560-1. [Google Scholar]

| Medium and Incubation Conditions | AFB2 (µg/kg) | STE (µg/kg) | ||||||||
|---|---|---|---|---|---|---|---|---|---|---|
| 2 Days | 7 Days | 14 Days | 21 Days | KW (P) | 2 Days | 7 Days | 14 Days | 21 Days | KW (P) | |
| CMA IN | 0.06 c ± 0.07 | 0.19 b ± 0.02 | 0.26 ab ± 0.09 | 0.29 a ± 0.09 | 0.003 | 0.03 c ± 0.02 | 0.15 b ± 0.03 | 0.16 b ± 0.03 | 0.22 a ± 0.06 | 0.001 |
| CMA-SC IN | 0.17 a ± 0.02 | 0.22 a ± 0.07 | 0.17 a ± 0.02 | 0.17 a ± 0.04 | 0.236 | 0 d ± 0 | 0.02 a ± 0.00 | 0.05 a ± 0.01 | 0.01 c ± 0.01 | ≤0.001 |
| CMA-GYE IN | 0.57 c ± 0.16 | 1984.25 b,* ± 68.8 | 2966.39 a,* ± 76.67 | 2983.54 a,* ± 65.91 | ≤0.001 | 0.07 d,* ± 0.02 | 13.83 b,* ± 1.29 | 16.75 a,* ± 1.42 | 4.83 c,* ± 0.58 | ≤0.001 |
| CMA-GYESC IN | 0.45 c ± 0.21 | 798.54 b,* ± 77.01 | 978.86 a,* ± 116.34 | 1037.78 a,* ± 91.53 | ≤0.001 | 0.22 d,* ± 0.04 | 3.84 a,* ± 0.58 | 1.47 c,* ± 0.16 | 3.15 b,* ± 0.41 | ≤0.001 |
| CMA RC | 0.09 c ± 0.06 | 0.12 c ± 0.06 | 0.19 ab ± 0.12 | 0.26 a ± 0.11 | 0.027 | 0 d ± 0 | 0.15 a ± 0.02 | 0.04c ± 0.01 | 0.11 d ± 0.01 | ≤0.001 |
| CMA-SC RC | 0.17 b ± 0.02 | 0.17 b ± 0.03 | 0.19 b ± 0.03 | 0.23 a ± 0.05 | 0.070 | 0 c ± 0 | 0.03 a ± 0.01 | 0.01 b ± 0.00 | 0.00 c ± 0.00 | ≤0.001 |
| CMA-GYE RC | 0.24 d,* ± 0.08 | 1546.95 c,* ± 113.30 | 1867.97 b,* ± 85.96 | 2805.11 a,* ± 138.82 | ≤0.001 | 0.15 d,* ± 0.13 | 17.36 a,* ± 1.19 | 10.25 b,* ± 1.29 | 5.16 c,* ± 0.92 | ≤0.001 |
| CMA-GYESC RC | 0.61 d,* ± 0.23 | 688.88 c,* ± 101.99 | 2131.86 b,* ± 119.28 | 1855.87 a,* ± 92.47 | ≤0.001 | 0.38 d,* ± 0.06 | 2.70 b,* ± 0.63 | 8.65 a,* ± 0.40 | 2.09 c,* ± 0.18 | ≤0.001 |
| Medium and Incubation Conditions | AFB2 (µg/kg) | STE (µg/kg) | ||||||||
|---|---|---|---|---|---|---|---|---|---|---|
| 2 Days | 7 Days | 14 Days | 21 Days | KW (P) | 2 Days | 7 Days | 14 Days | 21 Days | KW (P) | |
| SM-G IN | 0 d ± 0 | 17.78 c ± 0.90 | 59.48 b ± 0.90 | 75.55 a,* ± 1.55 | ≤0.001 | 0.57 d ± 0.13 | 1.16 c,* ± 0.27 | 2.18 b ± 0.58 | 2.31 a ± 0.48 | ≤0.001 |
| SM-GSC IN | 0 d ± 0 | 11.10 c ± 0.71 | 17.52 b ± 1.29 | 44.21 a,* ± 1.66 | ≤0.001 | 0.55 c ± 0.06 | 2.37 b,* ± 0.14 | 2.79 a ± 0.17 | 2.66 a ± 0.37 | 0.001 |
| SM-GYE IN | 0 d ± 0 | 28.69 c ± 1.35 | 39.32 b ± 0.52 | 64.40 a,* ± 0.90 | ≤0.001 | 0.56 b,* ± 0.07 | 1.59 a,* ± 0.29 | 1.61 a,* ± 0.45 | 1.44 a,* ± 0.22 | 0.003 |
| SM-GYESC IN | 0 d ± 0 | 16.99 c ± 1.60 | 61.89 b ± 1.99 | 96.84 a,* ± 5.44 | ≤0.001 | 0.28 d,* ± 0.16 | 2.64 b,* ± 0.73 | 4.10 a,* ± 0.72 | 2.63 b,* ± 0.21 | ≤0.001 |
| SM-G RC | 0 d ± 0 | 9.60 c ± 0.73 | 36.77 b ± 1.64 | 21.56 a ± 1.55 | ≤0.001 | 0.30d ±0.18 | 3.12 a ± 0.28 | 1.17 c,* ± 0.12 | 1.79 b,* ± 0.10 | ≤0.001 |
| SM-GSC RC | 0 d ± 0 | 4.95 c ± 0.31 | 14.44 b ± 2.90 | 21.18 a ± 1.58 | ≤0.001 | 0.29 c ± 0.17 | 2.67 b ± 0.17 | 2.78 b,* ± 0.35 | 3.33 a,* ± 0.65 | 0.001 |
| SM-GYE RC | 0 d ± 0 | 14.77 b ± 0.58 | 25.12 c ± 1.62 | 14.73 b ± 1.11 | ≤0.001 | 0.27 d ± 0.16 | 4.74 a,* ± 0.25 | 1.72 c ± 0.15 | 2.15 b ± 0.16 | ≤0.001 |
| SM-GYESC RC | 0 d ± 0 | 6.01 c ± 0.91 | 31.56 b ± 2.66 | 48.41 a ± 5.45 | ≤0.001 | 0.25 c ± 0.22 | 3.08 a,* ± 0.54 | 2.00 b ± 0.22 | 1.83 b ± 0.41 | ≤0.001 |
| T | Inhibition of Growth (% ING)/Inhibition of AFB1 Formation (% INA) | |||||||
|---|---|---|---|---|---|---|---|---|
| Incubator at 25 °C | Ripening Chamber | Incubator at 25 °C | Ripening Chamber | |||||
| t (Day) | CMA-SC | CMA-GYESC | CMA-SC | CMA-GYESC | SM-GSC | SM-GYESC | SM-GSC | SM-GYESC |
| 7 | 38.8/72.3 | 6.6/42.7 | 76.9/29.8 | 0/21.2 | 0/49.2 | 0/14.3 | 0/42.7 | 12.3/25.5 |
| 14 | 40.8/98.6 | 0/21.5 | 63.4/57.7 | 0/4.6 | 0/66.3 | 0/0 | 0/57.6 | 0/0 |
| 21 | 26.3/99.5 | 0/20.8 | 64.7/65.2 | 0/19.0 | 0/76.2 | 0/5.8 | 0/63.8 | 1.4/20.6 |
| Mycotoxin ID | Retention Time (min) | Precursor Ion | Cone Voltage (V) | Product Ion | Collision Energy (eV) | Recovery (%) | LOD (pg/column) | LOQ (pg/column) |
|---|---|---|---|---|---|---|---|---|
| AFB1 | 6.33 | 313.0 | 21 | 284.9 a 241.1 b | 38 22 | 93.2 ± 0.8 | 35 | 100 |
| AFB2 | 6.01 | 315.0 | 21 | 287.1 a 259.1 b | 38 22 | 90.5 ± 2.3 | 67 | 220 |
| AFG1 | 5.99 | 328.0 | 21 | 311.1 a 243.1 b | 38 22 | 92.3 ± 2.1 | 52 | 160 |
| AFG2 | 5.66 | 330.0 | 21 | 313.1 a 245.1 b | 38 22 | 91.8 ± 3.3 | 73 | 253 |
| STE | 8.64 | 325.0 | 21 | 281.0 a 210.0 b | 38 22 | 89.3 ± 1.7 | 70 | 220 |
Disclaimer/Publisher’s Note: The statements, opinions and data contained in all publications are solely those of the individual author(s) and contributor(s) and not of MDPI and/or the editor(s). MDPI and/or the editor(s) disclaim responsibility for any injury to people or property resulting from any ideas, methods, instructions or products referred to in the content. |
© 2024 by the authors. Licensee MDPI, Basel, Switzerland. This article is an open access article distributed under the terms and conditions of the Creative Commons Attribution (CC BY) license (https://creativecommons.org/licenses/by/4.0/).
Share and Cite
Zahija Jazbec, I.; Demšar, L.; Jeršek, B.; Polak, T. Meat Starter Culture Reduces Aspergillus parasiticus Production of Aflatoxins on Meat-Based and Salami Model Media. Toxins 2024, 16, 173. https://doi.org/10.3390/toxins16040173
Zahija Jazbec I, Demšar L, Jeršek B, Polak T. Meat Starter Culture Reduces Aspergillus parasiticus Production of Aflatoxins on Meat-Based and Salami Model Media. Toxins. 2024; 16(4):173. https://doi.org/10.3390/toxins16040173
Chicago/Turabian StyleZahija Jazbec, Iva, Lea Demšar, Barbka Jeršek, and Tomaž Polak. 2024. "Meat Starter Culture Reduces Aspergillus parasiticus Production of Aflatoxins on Meat-Based and Salami Model Media" Toxins 16, no. 4: 173. https://doi.org/10.3390/toxins16040173
APA StyleZahija Jazbec, I., Demšar, L., Jeršek, B., & Polak, T. (2024). Meat Starter Culture Reduces Aspergillus parasiticus Production of Aflatoxins on Meat-Based and Salami Model Media. Toxins, 16(4), 173. https://doi.org/10.3390/toxins16040173

